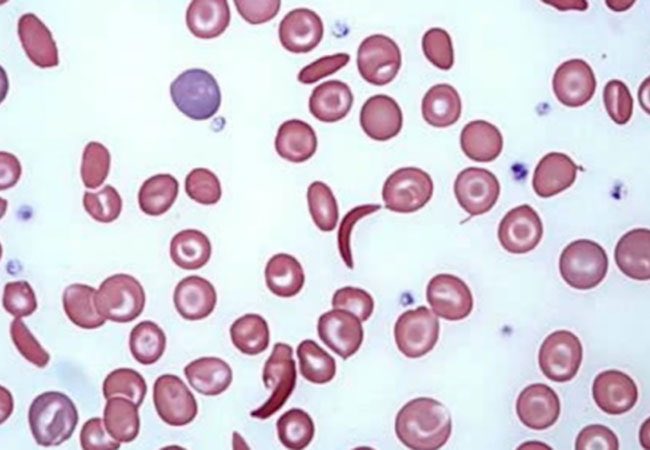

✨ في هذا الثريد راح أتكلم عن الانيميا المنجلية وماهي أسبابها، أعراضها، ومضاعفاتها، الاشخاص الاكثر عُرضة للاصابة فيها، كيف يتم تشخيصها أيضاً كيف يتم علاجها 👌🏻
🔍 أسبابها / Causes:
⁃ طفرة جينية / Gene Mutation
زي ما ذكرت بالتعريف فهو مرض وراثي متنحي أو الـ Autosomal Recessive، معنى انه لا بد من أصابة كلا الجينين حتى يُصاب الشخص بالانيميا المنجلية 👌🏻
⁃ طفرة جينية / Gene Mutation
زي ما ذكرت بالتعريف فهو مرض وراثي متنحي أو الـ Autosomal Recessive، معنى انه لا بد من أصابة كلا الجينين حتى يُصاب الشخص بالانيميا المنجلية 👌🏻
〽️ اذا كان الام أو الاب واحد منهم حامل أو مصاب والاخر سليم —> الاطفال راح يكونون حاملين للمرض ولكن غير مصابين 👌🏻
〽️ اذا كان الام و الاب كلاهما مصابين فهذا يعني أن —> الاطفال جميعهم راح يكونوا مصابين 👌🏻
〽️ اذا كان الام و الاب كلاهما مصابين فهذا يعني أن —> الاطفال جميعهم راح يكونوا مصابين 👌🏻
🔍 أعراضها / Symptoms:
⁃ أعراض فقر الدم العادية مثل: الارهاق وشحوب بالبشرة
⁃ ألم مفاجئ بالصدر / البطن / العظام و المفاصل
⁃ مشاكل بالرؤية / Vision Problems
⁃ انتفاخ باليدين والقدم / Swelling in Hands and feet
⁃ عدوى متكررة / Frequent Infection
⁃ أعراض فقر الدم العادية مثل: الارهاق وشحوب بالبشرة
⁃ ألم مفاجئ بالصدر / البطن / العظام و المفاصل
⁃ مشاكل بالرؤية / Vision Problems
⁃ انتفاخ باليدين والقدم / Swelling in Hands and feet
⁃ عدوى متكررة / Frequent Infection
🔍 مضاعفاتها / Complications:
⁃ ألم حاد بالصدر / Acute Chest Pain
⁃ سكتة دماغية / Stroke والسبب أن الخلايا المنجلية راح تقفل مجرى الدم للدماغ
⁃ ضرر / تلف بالاعضاء / Organ Damage
⁃ العمى / Blindness
⁃ حصى المرارة / Gallstone
⁃ ألم حاد بالصدر / Acute Chest Pain
⁃ سكتة دماغية / Stroke والسبب أن الخلايا المنجلية راح تقفل مجرى الدم للدماغ
⁃ ضرر / تلف بالاعضاء / Organ Damage
⁃ العمى / Blindness
⁃ حصى المرارة / Gallstone
🔍 الاشخاص الاكثر عُرضة للاصابة فيها :
⁃ اذا كان هناك تاريخ عائلي / Family History لهذا النوع من الانيميا
⁃ اذا كان هناك تاريخ عائلي / Family History لهذا النوع من الانيميا
🔍 تشخيصها / Diagnosis:
1️⃣ تحليل صورة دم كاملة / Complete Blood Count CBC
راح نشوف عدد خلايا الدم الحمراء ومتوسط حجمها 👌🏻 ايضاً الـ Hemoglobin Content
خلايا الدم البيضاء / WBCs راح تكون مرتفعه —> Left Shift
1️⃣ تحليل صورة دم كاملة / Complete Blood Count CBC
راح نشوف عدد خلايا الدم الحمراء ومتوسط حجمها 👌🏻 ايضاً الـ Hemoglobin Content
خلايا الدم البيضاء / WBCs راح تكون مرتفعه —> Left Shift
3️⃣ Hemoglobin Electrophoresis
وهذا يُعتبر Confirmatory Test راح نبحث عن Hemoglobin جديد يُسمى بـ "Hemoglobin "S
4️⃣ Iron Profile
مرضى الدم المنجلي راح يعانون من إرتفاع بالحديد بشكل مستمر والسبب كثرة نقل الدم لهم 👍🏻
وهذا يُعتبر Confirmatory Test راح نبحث عن Hemoglobin جديد يُسمى بـ "Hemoglobin "S
4️⃣ Iron Profile
مرضى الدم المنجلي راح يعانون من إرتفاع بالحديد بشكل مستمر والسبب كثرة نقل الدم لهم 👍🏻
🔍 علاجها / Treatment:
⁃ أدوية / Medications
⁃ نقل دم / Blood Transfusion
⁃ زراعة خلايا جذعية / Stem Cell Transplantation 👇🏼
نوع جديد من أنواع الـ Gene Therapy 🧬
⁃ أدوية / Medications
⁃ نقل دم / Blood Transfusion
⁃ زراعة خلايا جذعية / Stem Cell Transplantation 👇🏼
نوع جديد من أنواع الـ Gene Therapy 🧬
انتهى
موفقين 👍🏻
موفقين 👍🏻
Loading suggestions...